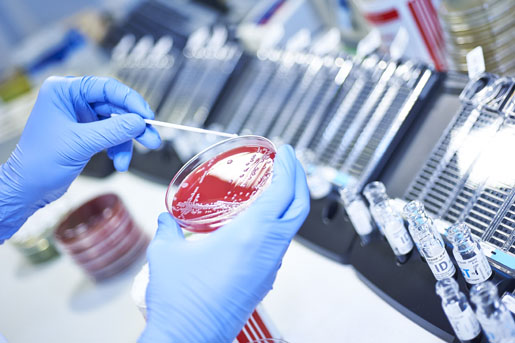
instytut oderland th

IMD Oderland oferuje kompletne spektrum nowoczesnej diagnostyki laboratoryjnej, mikrobiologicznej i transfuzjologicznej, wraz z biologią molekularną.
Po raz kolejny mamy przyjemność zaprosić Państwa do skorzystania z promocyjnej oferty badań. W dniach 23.11.2015 – 04.12.2015 wykonamy zestaw analiz pozwalających ocenić podstawowe funkcje organizmu (morfologia z rozmazem; poziom żelaza; wskaźniki stanu zapalnego: CRP, OB; parametry cukrzycowe: glukoza, HbA1c; elekrolity: sód, potas, wapń, chlorki; gospodarkę tłuszczową: cholesterol, triglicerydy, HDL, LDL; badania tarczycy: TSH; wątroby: ALAT i nerek: kreatynina, GFR, kwas moczowy).
Cena promocyjna wynosi 15 EUR (rzeczywista wartość wg. cennika: 35,- EUR). Badania są wykonywane z krwi (pobranie na miejscu). Należy przyjść na czczo.
REJESTRACJA: W celu sprawnej obsługi pacjentów prosimy o rejestrację telefoniczną w godz. 10.00-13.00, od poniedziałku do piątku, pod numerem telefonu: 00 49 335 55 81 106 (kontakt w języku polskim).

Kontakt z laboratorium:
- Institut für Medizinische Diagnostik Oderland
- Am Kleistpark 1
- 15230 Frankfurt (Oder)
- tel. 00 (49) 335 55 81106 (rozmawiamy po polsku)